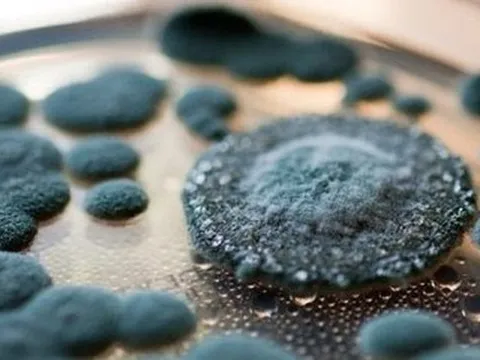
3 loại nấm mốc có thể xuất hiện trong nhà khiến bạn mắc bệnh

Sức khỏe
4 dấu hiệu cho thấy mật ong 100% nguyên chất
Sử dụng mật ong giả có thể khiến người dùng gặp các vấn đề về bệnh tiểu đường, tim mạch, gây mỡ nội tạng... Do đó, chúng ta cần nắm được kiến thức chọn mật ong trước khi quyết định có mua hay không.
Cảnh báo căn bệnh nguy hiểm đàn ông hay mắc phải
Ở giai đoạn bệnh khởi phát, hơn 75% trường hợp không có triệu chứng và có người buộc phải cắt cụt chi để bảo toàn tính mạng khi mắc bệnh này.
Có cần tiêm vắc xin phòng COVID-19 mũi 5 không?
Theo các chuyên gia về y tế, việc tiêm vắc xin mũi 5 phòng COVID-19 phụ thuộc vào biến chủng, nguy cơ lây lan tiềm ẩn của dịch COVID-19. Thời điểm hiện nay có cần tiêm mũi 5 và nếu có thì ai cần?
Hà Nội ghi nhận số ca mắc sốt xuất huyết tuần qua giảm 11%
Ở Hà Nội số mắc sốt xuất huyết giảm 11% so với tuần trước đó, tuy nhiên số tử vong không giảm.
Mỹ: Tìm ra thuốc mới trị được cả ung thư và COVID-19
Các nhà nghiên cứu Mỹ đã tìm ra một cơ chế đặc biệt hỗ trợ sự lây lan của virus SARS-CoV-2 trong cơ thể, có thể bị khóa bởi một loại thuốc họ đang nghiên cứu để chống ung thư.
3 loại nấm mốc có thể xuất hiện trong nhà khiến bạn mắc bệnh
Nhiều người nghĩ rằng nấm mốc chỉ xuất hiện ở những ngôi nhà cũ, nhưng thực tế, bất kỳ ngôi nhà nào cũng có thể bị nấm mốc do nhiều nguyên nhân.
Thiếu nhạc trưởng phát triển ngành dược - Chậm nhịp, yếu thế
LTS: Những năm gần đây, ngành dược Việt Nam có sự thay đổi mạnh mẽ nhờ nguồn đầu tư lớn từ các doanh nghiệp (DN) trong nước cũng như nước ngoài. Dù được đánh giá có nhiều cơ hội phát triển, nhưng ngành dược lại gặp nhiều thách thức khi nguồn nguyên liệu phụ thuộc từ nước ngoài, công tác nghiên cứu và phát triển các loại thuốc bằng sáng chế còn hạn chế và chỉ có thể sản xuất thuốc gốc… khiến ngành dược mãi chưa vươn tầm.
Uống thuốc nam không rõ nguồn gốc, u ác sau phúc mạc to nhanh và xâm lấn phức tạp
Các bác sĩ Khoa Ung bướu, Bệnh viện Đa khoa tỉnh Quảng Ninh vừa phẫu thuật bóc tách u ác tính kèm khối tá tụy ra khỏi cơ thể, giúp người bệnh phục...
Bệnh dại gây chết người nhưng phòng tránh được
Bệnh dại là bệnh truyền nhiễm nguy hiểm do virus dại gây ra, khi đã lên cơn dại, kể cả động vật và người đều tử vong.
Nguy kịch vì dùng thuốc nam chữa ung thư, thận hư
Không tuân thủ phác đồ của bác sĩ mà tự ý chuyển sang dùng thuốc nam không rõ nguồn gốc, nhiều bệnh nhân nhập viện nguy kịch, thậm chí phải thay thận.
Ngâm chân với loại nước này trước khi đi ngủ không chỉ giúp khí huyết lưu thông, ngủ ngon hơn mà còn cải thiện được 3 vấn đề khác của cơ thể
Không chỉ giúp ngủ ngon hơn, ngâm chân bằng loại nước này trước khi ngủ còn đem lại nhiều lợi ích khác cho sức khỏe.
Nên ăn gì để đủ chất dinh dưỡng trong ngày đông lạnh giá?
Những ngày gần đây, miền Bắc đã đón khá nhiều đợt gió mùa đông bắc khiến nhiệt độ giảm sâu. Vậy nên ăn gì để đủ chất dinh dưỡng và tăng sức đề kháng?
Những dấu hiệu sớm cảnh báo ung thư buồng trứng dễ bị bỏ qua
Những dấu hiệu sớm cảnh báo ung thư buồng trứng rất dễ bị bỏ qua, bởi chúng phổ biến và dễ bị nhầm với tình trạng sức khỏe khác.
Không muốn sức khỏe ngày càng yếu đi, bỏ ngay 8 thói quen ăn uống âm thầm "bào mòn" khả năng miễn dịch này
Những thói quen hàng ngày tuy nhỏ nhưng về lâu dài có thể ảnh hưởng rất lớn đến sức khỏe của bạn. Dưới đây là 8 thói quen ăn uống bạn nên bỏ ngay để duy trì hệ miễn dịch khỏe.